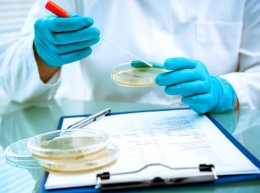
ก้าวสู่การประเมินความเสี่ยงด้านความปลอดภัยอาหารด้วยมุมมองเชิงรุกและข้อมูลที่แม่นยำ Stepping Towards Proactive Food Safety Risk Assessment with Accurate Data

ก้าวสู่การประเมินความเสี่ยงด้านความปลอดภัยอาหารด้วยมุมมองเชิงรุกและข้อมูลที่แม่นยำ Stepping Towards Proactive Food Safety Risk Assessment with Accurate Data
275 Views |

ก้าวสู่การประเมินความเสี่ยงด้านความปลอดภัยอาหารด้วยมุมมองเชิงรุกและข้อมูลที่แม่นยำ
Stepping Towards Proactive Food Safety Risk Assessment with Accurate Data
By: ภณิดา พิสัยสวัสดิ์
Panida Pisaisawat
Regional Technical Support Manager
Hygiena
ppisaisawat@hygiena.com
การบริหารความเสี่ยงด้านความปลอดภัยอาหารในอุตสาหกรรมยุคใหม่ ต้องอาศัยมุมมองแบบองค์รวม การดำเนินงานเชิงรุก และการใช้ข้อมูลที่ถูกต้องและตรวจสอบได้ ความเสี่ยงสามารถเกิดขึ้นได้ตลอดห่วงโซ่การผลิต ตั้งแต่วัตถุดิบ กระบวนการผลิต ไปจนถึงผลิตภัณฑ์สำเร็จรูป ทั้งในรูปแบบทางกายภาพ เคมี และชีวภาพ
แหล่งความเสี่ยงสำคัญคือ พื้นที่และสภาพแวดล้อมการผลิต โดยเฉพาะบริเวณอับชื้นหรือทำความสะอาดยาก ซึ่งอาจเป็นแหล่งสะสมของเชื้อก่อโรค การควบคุมจึงควรดำเนินการตามแนวทาง 5-Point Pathogens’ Control Plan ควบคู่กับการจัดการความเสี่ยงในกระบวนการผลิต ผ่านการกำหนด CCPs, OPRPs การจัด Zoning และการป้องกันการปนเปื้อนข้ามอย่างเคร่งครัด
สำหรับความปลอดภัยของผลิตภัณฑ์สำเร็จรูป ซึ่งเป็นด่านสุดท้าย โรงงานอาหารได้นำเทคโนโลยี Rapid Testing มาใช้เพื่อเพิ่มความรวดเร็วในการตัดสินใจและลดความเสี่ยงจากการร้องเรียนหรือการเรียกคืนสินค้า
หัวใจสำคัญคือการติดตาม ตรวจสอบ และตัดสินใจเชิงรุกผ่านการตรวจ ATP และการตรวจจุลินทรีย์ เมื่อพบความผิดปกติ ต้องมีการแก้ไขและตรวจยืนยันซ้ำอย่างเป็นระบบสู่การเชื่อมโยงข้อมูลทั้งหมดผ่านระบบวิเคราะห์ข้อมูล เพื่อยกระดับความปลอดภัยอาหารอย่างมั่นคงและยั่งยืนในระยะยาว
Modern food safety risk management requires a holistic, proactive approach supported by accurate and verifiable data. Risks can arise across the entire food value chain—from raw materials and processing to finished products—and may involve physical, chemical, or biological contamination.
Key risk sources include the production environment, especially humid or hard-to-clean areas that may harbor pathogens. Effective control should follow a 5-Point Pathogens’ Control Plan, alongside robust risk management within the production process, including defined CCPs, OPRPs, zoning, and strict cross-contamination prevention.
As the final control point, finished product safety is critical. Rapid testing technologies are increasingly used to accelerate decision-making and reduce the risk of complaints or product recalls.
At the core of this system is continuous monitoring and proactive decision-making through ATP and microbiological testing. Integrating these data into a unified analysis system enables real-time visibility of risks and supports informed actions to strengthen food safety performance sustainably.